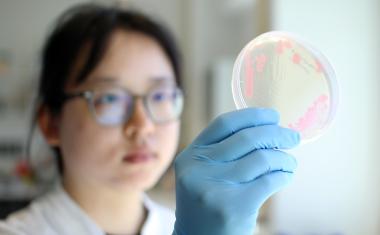
Photo

Neues Magazin „Wir für Sie“
Die Lahn-Dill-Kliniken starten mit „Wir für Sie“ ein neues Magazin für die Region.

Die Lahn-Dill-Kliniken starten mit „Wir für Sie“ ein neues Magazin für die Region.

Prof. Dr. med. Annegret Kuhn, MBA, startet als Medizinische Geschäftsführerin am Klinikum Bielefeld.

Zum 1. April übernimmt Maik Christiansen die Position der Kaufmännischen Leitung der DIAKO Nordfriesland. Der 41-jährige, gebürtige Husumer leitete bisher das Finanz- und Rechnungswesen.

Die Vinzenz Kliniken Wien haben kürzlich das CLMM zur Medikamentenversorgen implantiert und beliefern ihre Stationen mit neu verblisterten Arzneimitteln.

Der Aufsichtsrat der Kliniken der Stadt Köln hat Dr. Tobias Klein zum neuen Chefarzt der Klinik für Kinder- und Jugendchirurgie und Kinderurologie am Kinderkrankenhaus Amsterdamer Straße bestellt.

ETH-Professor Ruedi Aebersold erhält zusammen mit John Yates vom Scripps Research Institute in La Jolla, USA, und Matthias Mann vom Max-Planck-Institut Martinsried, Deutschland, den Canada Gairdner International Award.

Dr. Raphael Bocklage ist neuer Chefarzt am St. Marienhospital Vechta: Mit ihm gewinnt das Krankenhaus einen ausgewiesenen Experten für Orthopädie und Unfallchirurgie.

Viele Krankenhäuser stehen vor der strategischen und praktischen Herausforderung, alternative Lösungen zu SAP zu finden.

Klüh Catering engagiert sich als Partner im Projekt „Green Hospital Food“.

Mit den digitalen Lösungen von Doctolib lassen sich Prozesse optimieren und das Personal entlasten.

Prof. Dr. Christine Dierks übernimmt zum 1. April die Leitung der Klinik für Hämatologie und Internistische Onkologie im Klinikum Lippe.

IT-Lösungen für die Radiologie, Pathologie, Intensivmedizin und Kardiologie. Vereinbaren Sie jetzt Ihren Gesprächstermin.

Der Deutsche Krebspreis wird jährlich in den Kategorien „Translationale Forschung“, „Klinische Forschung“, „Experimentelle Forschung“ und „Versorgungsforschung“ vergeben.

Die Interdisziplinäre Bettenstation und die kardiologische Überwachungsstation sollen im Mai 2027 in Betrieb gehen.

Was passiert, wenn die Ingenieurskunst eines Global Players auf ein innovatives Desinfektions-Startup trifft?

Die Rudolf Schülke Stiftung zeichnet UKSH-Hygienikerin für Studie zur Infektionsprävention auf Intensivstationen aus.

Am Herzzentrum des Universitätsklinikums Freiburg ist weltweit erstmals eine neuartige Angiografie-Anlage im klinischen Einsatz.

Eine Studie der Universitätsmedizin Mainz zeigt, dass Patienten mit akuter Lungenembolie von einer kathetergestützten, ultraschallunterstützten Therapie profitieren.

Ein Forscherteam der Charité Berlin hat einen Test entwickelt, der den Chronotyp anhand von Haarwurzeln bestimmt. Die Methode zeigt, dass Frauen und Männer sich in ihren Biorhythmen leicht unterscheiden.

Mit der erfolgreichen EMAS Zertifizierung von 27 ihrer rund 100 Einrichtungen verankert Agaplesion Umweltschutz nach höchstem europäischem Standard.
FZB und CAU arbeiten standortübergreifendend zusammen zur Erforschung der Plastizität von Antibiotikaresistenzen bei bakteriellen Krankheitserregern.

Es war spannend bis zuletzt: der Bundesrat stimmte dem Krankenhausreform-Anpassungsgesetz zu.

Budget, Personal und Zeit sind in Kliniken chronisch knapp. Kommen zusätzlich gesetzliche Anforderungen für mehr IT-Sicherheit hinzu, bedeutet das zunächst Mehraufwand.

Die Deutsche Krankenhausgesellschaft befürchtet starke Leistungseinschränkungen für die Kliniken

Nach mehr als zwei Jahrzehnten verlässt Dr. Holger Göbel das Sana Klinikum Lichtenfels als Chefarzt der Gastroenterologie und ärztlicher Direktor.

Prof. Dr. Lutz Hager, Professor für Management im Gesundheitswesen an der SRH Fernhochschule wurde erneut zum Vorstandsvorsitzenden des Bundesverbands Managed Care gewählt.

PSI-Forscher haben einen lichtaktivierten Wirkstoff gegen Bluthochdruck untersucht und beobachtet, wie sich dessen Molekülform verändert und damit seine Wirkung beeinflusst.

Der BVMed begrüßt die Zustimmung des Europäischen Parlaments zu Änderungen im Rahmen des KI-Omnibus. Der MDR als sektoraler Regulierungsrahmen wird Vorrang bei KI-basierten Medizinprodukten eingeräumt.

Das Klinikum Stuttgart entwickelt eine innovative Virtual-Reality-Trainingsumgebung für Notfalleinsätze.

Dr. med. Frank Templin eröffnet zum 7. April 2026 in den Räumlichkeiten der ehemaligen Notaufnahme am Runden Berge seine neue Praxis für Chirurgie.

Forscher der Ruhr-Universität Bochum entwickelten einen neuen Kupfer-Wirkstoff, der in Polymernanopartikeln verpackt und im Tumor durch Licht aktiviert wird. So werden Tumorzellen gezielt zerstört.

Eine frühzeitige Diagnose verbessert die Heilungschancen bei Leberkrebs. Ein Forscherteam hat ein KI-Modell entwickelt, das anhand klinischer Routinedaten das individuelle Leberkrebsrisiko vorhersagt.

KfH begrüßt Reform des Transplantationsgesetzes, denn
mehr als 6.000 Menschen warteten Ende 2025 auf eine Nierenspende.

Kliniken erhalten erstmals eine wissenschaftlich validierte, automatische Wundanalyse direkt am Ort der Behandlung – nahtlos eingebettet in die digitale Patientenakte.

Die Deutsche Gesellschaft für Arbeitsmedizin und Umweltmedizin zeichnete André Klußmann, Professor für Arbeitswissenschaft an der HAW Hamburg, mit der Joseph-Rutenfranz-Medaille aus.